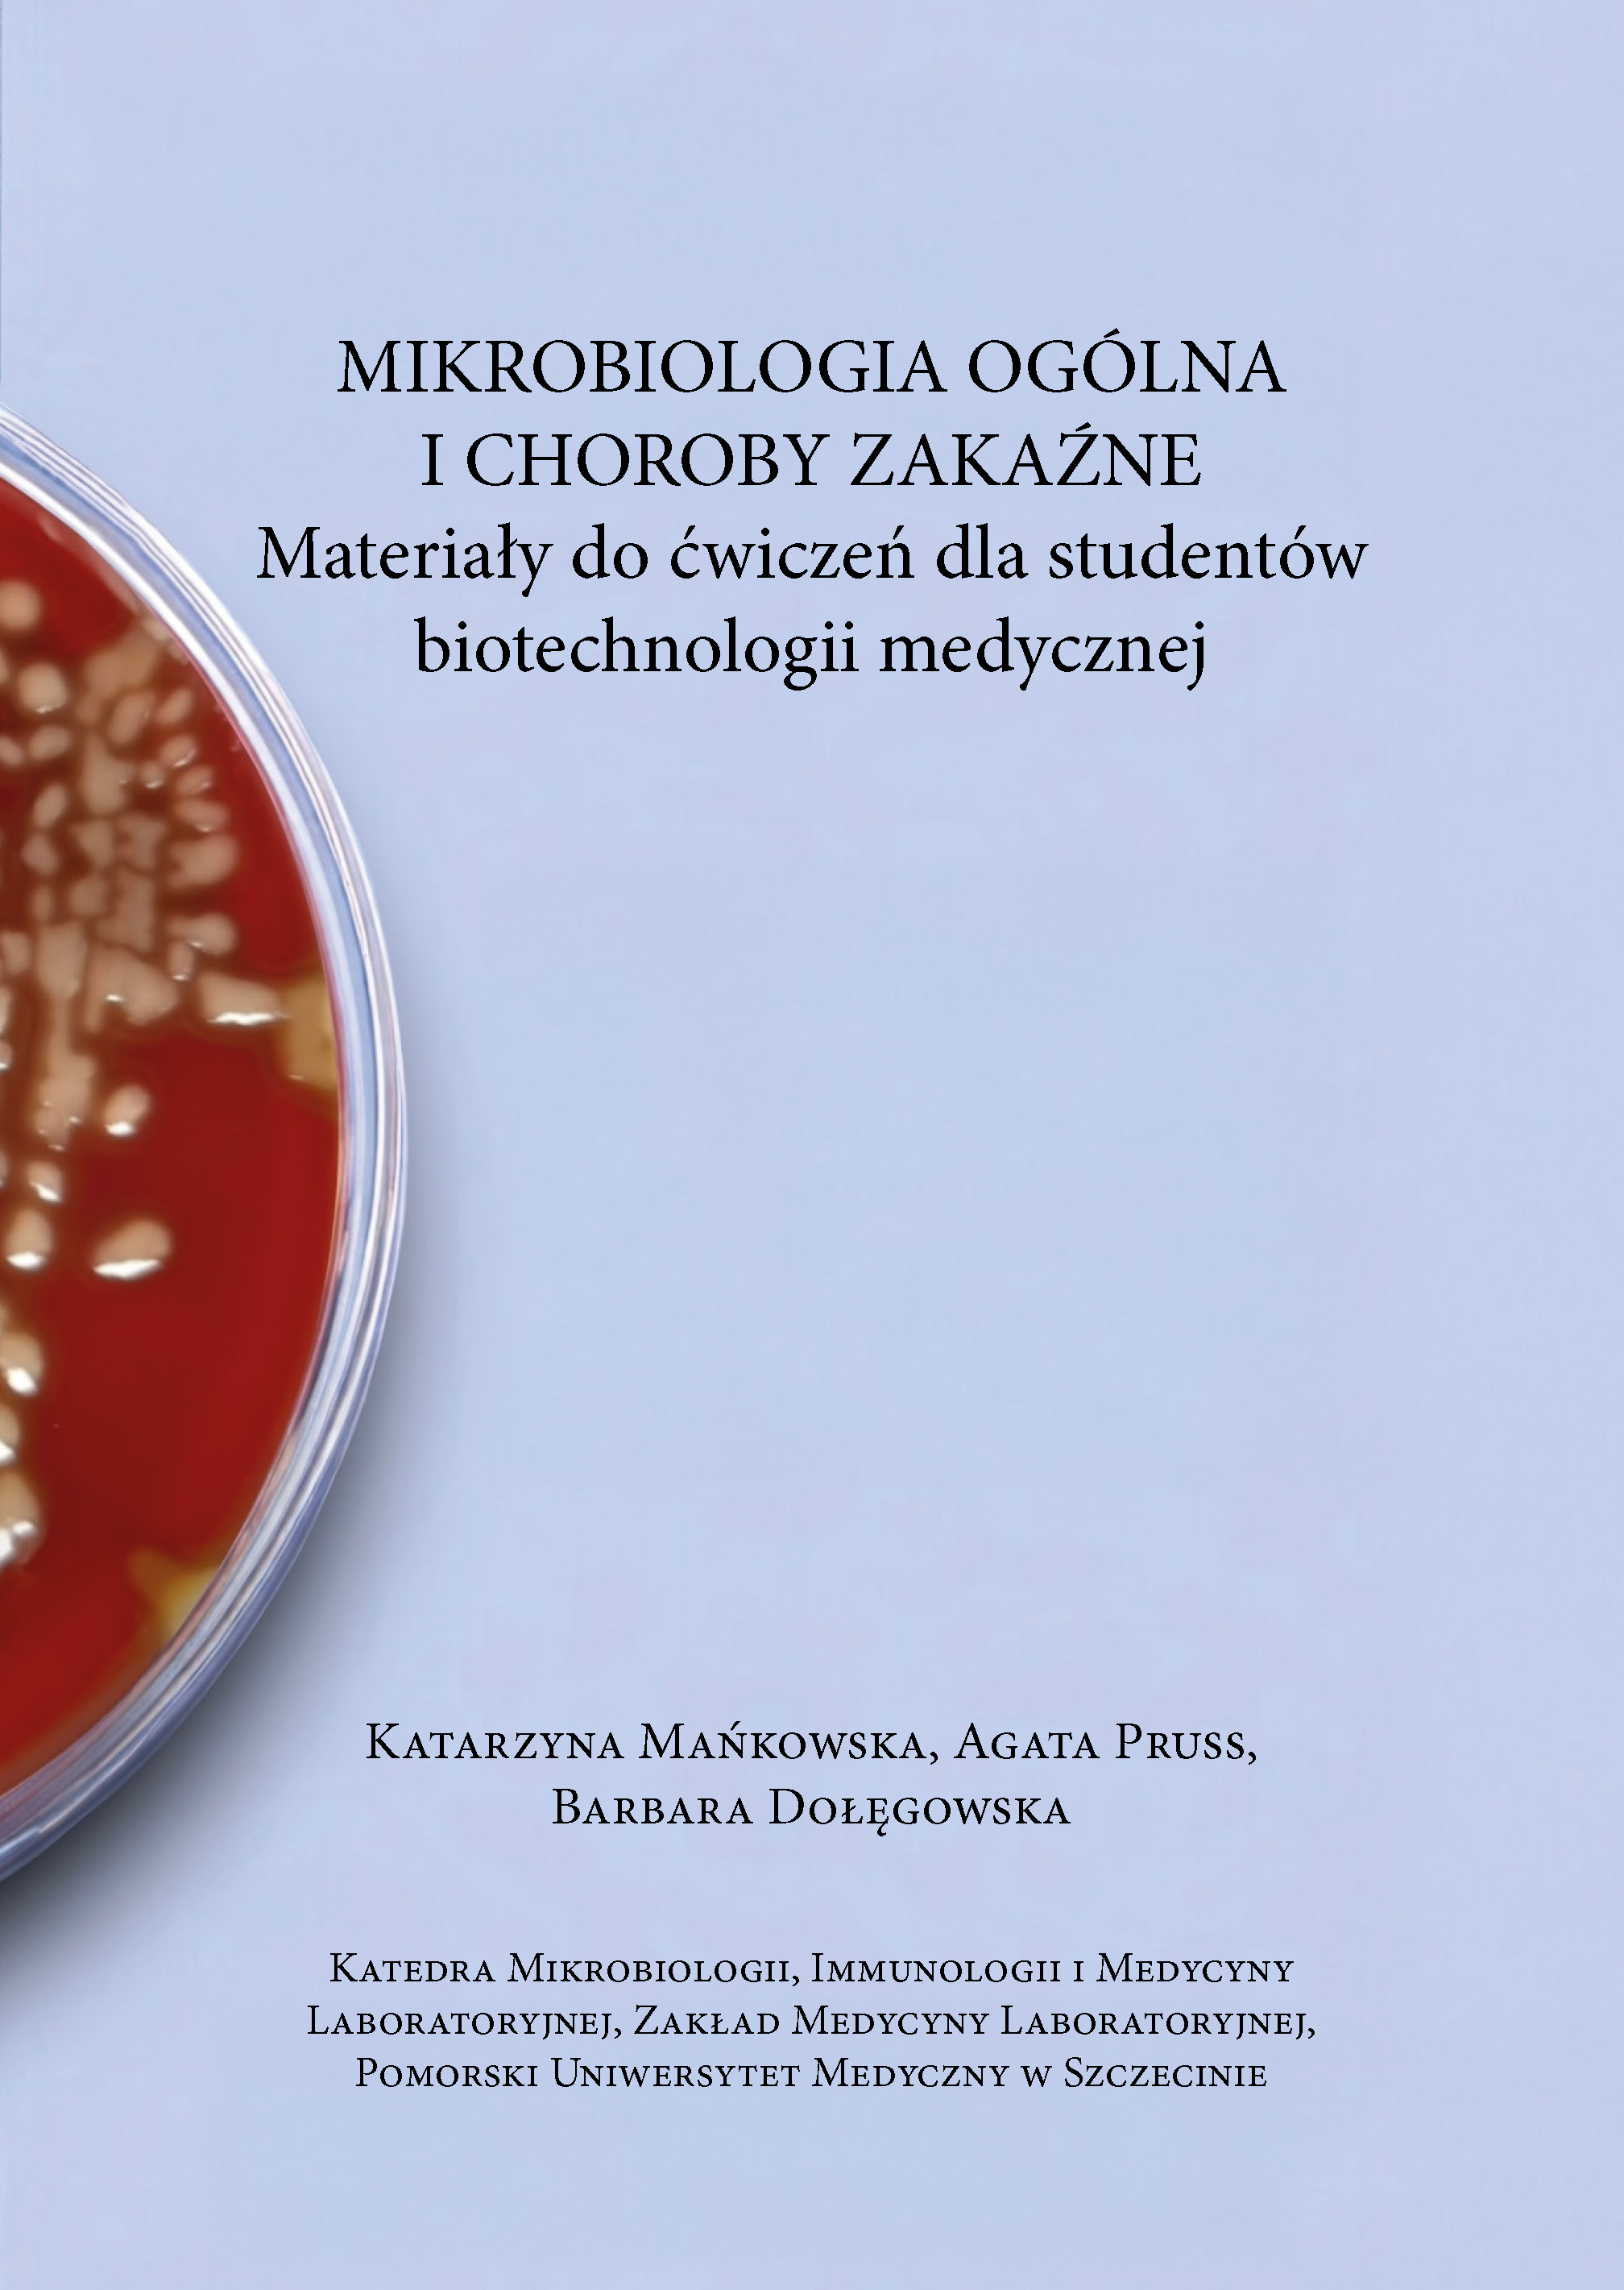

Sprzedaż
Książki można kupić w siedzibie Wydawnictwa oraz zamawiać drogą mailową.
Jak zamawiać książki w naszym Wydawnictwie?
- Napisz maila na adres: ksiazki@pum.edu.pl. Podaj autora i tytuł książki, którą chcesz kupić, oraz poinformuj nas, czy odbierzesz zamówienie osobiście, czy prosisz o zamówienie z wysyłką.
- W odpowiedzi zwrotnej dostaniesz instrukcję dotyczącą dalszych kroków (dane do przelewu, tytuł przelewu, dokładną kwotę itp.).
Uwaga! Nie dokonuj przelewu, dopóki nie dostaniesz wspomnianej odpowiedzi.
Sprzedaż bezpośrednia w godzinach 8:00-15:00, przyjmujemy płatność tylko kartą.
Adres: 71-422 Szczecin, ul. Piotra Skargi 15 (wejście od ul. Ogińskiego), pokój nr 2
Dane do przelewu:
Pomorski Uniwersytet Medyczny w Szczecinie
ul. Rybacka 1, 70-204 Szczecin
Santander Bank Polska Oddział Szczecin
Nr konta: 06 1090 1492 0000 0001 0053 7752
Tytuł przelewu: Wydawnictwo PUM
Niniejsza strona nie stanowi oferty handlowej w rozumieniu art. 66 §1 Kodeksu Cywilnego oraz innych właściwych przepisów prawnych.
WAŻNE! PAMIĘTAJ, PODAJ NIP!
Uprzejmie informujemy, że od 1 stycznia 2020 r. wystawianie faktury dla podmiotów prowadzących działalność gospodarczą jest możliwe tylko dla paragonów zawierających prawidłowy numer NIP, tj. numer, za pomocą którego nabywca towarów lub usług jest zidentyfikowany na potrzeby podatku czy podatku od towarów i usług (Podstawa prawna: art. 106b ust.5 Ustawy z dnia 11 marca 2004 r. o podatku od towarów i usług (Dz.U. z 2018 r. poz. 2174, z późn. zm.)
![]() |
Fizjoterapia kliniczna Fizjoterapia kliniczna – praktyczne aspekty terapii
|
![]() |
Fizjoterapia kliniczna Fizjoterapia kliniczna – praktyczne aspekty terapii
|
![]() |
Katarzyna Mańkowska, Agata Pruss, Barbara Dołęgowska Mikrobiologia ogólna i choroby zakaźne. Materiały do ćwiczeń dla studentów biotechnologii medycznej
ISBN 978-83-64906-74-9, format B5, oprawa miękka, 160 s.
|
![]() |
Postępy w medycynie i inżynierii biomedycznej wyzwaniem dla współczesnej rehabilitacji.
|
![]() |
Joanna Stępniewska, Ewa Kwiatkowska, Jacek Różański, Leszek Domański Badanie podmiotowe jako element egzaminu OSCE
ISBN 978-83-64906-76-36, format B5, oprawa zeszytowa, 30 s.
|
![]() |
Dziecko pozbawione opieki rodziców biologicznych. Medyczne, psychologiczne, społeczne i prawne aspekty dzieci i młodzieży przebywających w pieczy zastępczejpod red. Marty Giezek i Agnieszki Nieradko-Heluszko ISBN 978-83-64906-68-8, format B5, oprawa miękka, 192 s.
|
![]() |
Hipermobilność stawów. Aspekty klinicznepod red. Łukasza Kołodzieja, Eweliny Żyżniewskiej-Banaszak i Magdaleny Gębskiej ISBN 978-83-64906-41-1, format B5, oprawa miękka, 92 s.
|
![]() |
Żywność wysokoprzetworzonapod red. Izabeli Gutowskiej i Adama Grzegrzółki ISBN 978-83-64906-71-8, format B5, oprawa miękka, 145 s.
|
![]() ![]() ![]() ![]() |
Zestaw książekŻywność wysokoprzetworzona | ISBN 978-83-64906-71-8 cena: 70,00 zł |
![]() |
Dominika Mocarz, Karolina Woronko, Ewa Siwiec, Krzysztof Lubiński, Tomasz Huzarski, Jan Lubiński Biała księga arsenu
ISBN 978-83-64906-62-6, format B5, oprawa miękka, 171 s.
|
![]() |
Wojciech Kozik, Tadeusz Sulisz, Zbigniew Ziętek Przewodnik do ćwiczeń z anatomii prawidłowej człowieka
ISBN 978-83-64906-63-3, format B5, oprawa miękka, 162 s.
|
![]() |
Filozofia opieki farmaceutycznej. Philosophy of pharmaceutical carepod red. Izabeli Gutowskiej i Anny Żuk ISBN 978-83-64906-67-1, format B5, oprawa miękka, 235 s.
|
|
pod red. Krzysztofa Kozłowskiego
ISBN 978-83-64906-64-0, format B5, oprawa miękka, 215 s.
cena: 127 zł |
|
|
|
Żywność wspierająca odpornośćpod red. Izabeli Gutowskiej i Adama Grzegrzółki ISBN 978-83-64906-65-7, format B5, oprawa miękka, 107 s.
|
|
|
Humanizm i medycynapod red. Renaty Elżbiety Paligi ISBN 978-83-64906-60-2, format B5, oprawa miękka, 99 s.
|
|
|
Humanistyka w farmacjipod red. Izabeli Gutowskiej i Anny Żuk ISBN 978-83-64906-61-9, format B5, oprawa miękka, 160 s.
|
|
|
Marta Germanowicz-Pakuła Historia kosmetologii na przełomie XIX I XX wiekuISBN 978-83-64906-56-5, format B5, oprawa miękka, 154 s.
Zarys historii ozdabiania ciałapod red. Lilianny Wdowiak ISBN 978-83-649-06-12-1, format B5, oprawa twarda, 445 s. cena 40 zł (cena za zestaw) |
![]() |
Świat histologii dla studentów kierunków medycznychpod red. Barbary Wisziewskiej i Aleksandry WilkISBN 978-83-64906-50-3, format B5, oprawa miękka, 130 s.
|
![]() |
The world of histology for medicine studentsedited by Barbara Wiszniewska and Aleksandra WilkISBN 978-83-64906-52-7, format B5, oprawa miękka, 130 s.
|
![]() |
Małgorzata Geszke-Moritz, Michał Moritz Cechy diagnostyczne wybranych sproszkowanych substancji roślinnych
ISBN 978-83-64-906-48-0, format A4, oprawa miękka, 48 s.
|
![]() |
Paulina Roszkowska
|
![]() |
Przymus bezpośredni stosowany wobec osób z zaburzeniami psychicznymi
ISBN 978-83-64906-45-9, format B5, oprawa miękka, 164 s.
|
![]() |
Nadciśnienie tętnicze – interdyscyplinarne podejście
ISBN 978-83-64906-49-7, format B5, oprawa miękka, 140 s.
|
|
|
Immunologia. Teoretyczny i praktyczny przewodnik
ISBN 978-83-64-906-38-1, format B5, oprawa miękka, 144 s.
|
![]() |
Immunologia. Zeszyt ćwiczeń
ISBN 978-83-64-906-40-4, format B5, oprawa zeszytowa, 60 s.
|
![]() |
Małgorzata Geszke-Moritz, Michał Moritz
|
![]() |
Michał Moritz, Małgorzata Geszke-Moritz
|
![]() |
Współczesne oblicze cukrzycy i jej leczenie
ISBN 978-83-64906-42-8, format B5, oprawa miękka, 131 s.
|
![]() |
Grzegorz Trybek, Anna Grzywacz
|
|
|
Uniwersytecka protetyka stomatologiczna na Pomoru Zachodnim w latach 1949-2017pod red. Bogumiły Frączak
ISBN 978-83-64906-27-5, format B5, oprawa miękka, 120 s.
(Fragment dostępny przez platformę PPM PUM)
cena 40 zł |
![]() |
Maciej Hałasa
|
|
|
Wybrane problemy zdrowotne małego dziecka oraz zaburzenia karmienia u niemowląt i dzieci – ujęcie interdyscyplinarne
ISBN 978-83-64906-26-8, format B5, oprawa miękka, 218 s.
|
![]() |
Polska Baza Genetyczna Ofiar Totalitaryzmów
|
![]() |
Almanach kobiet chirurgów dziecięcych. Historia polskiej chirurgii dziecięcej (1909-2009) przez pań chirurgów dziecięcych przypadki pisana
ISBN 978-83-64906-17-6, format A4, oprawa twarda, 507 s.
|
![]() |
Uniwersytet i medycyna w przeddzień globalnej korporacji i medycyny in silico
ISBN 978-83-64906-22-0, format B5, oprawa miękka i twarda, 368 s.
|
![]() |
70 lat Pomorskiego Uniwersytetu Medycznego w Szczecinie
ISBN 978-83-649-06-19-0, format 290mmx290mm, oprawa twarda, 240 s.
|
![]() |
Zarys historii ozdabiania ciała
ISBN 978-83-649-06-12-1, format B5, oprawa twarda, 445 s.
|
![]() |
Przeszczepianie wątroby, wyd. II
ISBN 978-83-64906-16-9, format B5, oprawa twarda, 395 s.
|
![]() |
Książka ZARYS ENDOKRYNOLOGII KLINICZNEJ |
![]() |
PODSTAWY DIABETOLOGII dla studentów medycyny i lekarzy praktyków
ISBN 978-83-64906-08-4, format B5, oprawa miękka, 144 s.,
|
![]() |
Marcin Milchert, Andreas P. Diamantopoulos, Marek Brzosko
|
![]() |
Bernadeta Bilicka
|
![]() |
Agnieszka Kordek
|
![]() |
EDUKACJA POPORODOWA
ISBN 978-83-61517-99-3, format B5, oprawa miękka, 210 s.,
|
![]() |
Iwona Teul
|
![]() |
ORAL MEDICINE
ISBN 978-83-61517-98-6, format B5, oprawa miękka, 106 s.,
|
![]() |
GINEKOLOGIA od teorii do praktyki
ISBN 978-83-61517-94-8, format B5, oprawa miękka, 336 s.,
|
![]() |
CONTEMPORARY DENTISTRY
ISBN 978-83-61517-95-5, format B5, oprawa miękka, 92 s.,
|
![]() |
Elżbieta Ziółkowska-Rudowicz, Aleksandra Kładna
|
![]() |
STARZEJĄCE SIĘ SPOŁECZEŃSTWO WYZWANIEM DLA ZDROWIA PUBLICZNEGO
ISBN 978-83-61517-92-4, format B5, oprawa miękka, 180 s.,
|
![]() |
CLINICAL RHEUMATOLOGY
ISBN 978-83-61517-70-2, format B5, oprawa twarda, 304 s.,
|
![]() |
UKŁAD PŁCIOWY MĘSKI. BADANIA KLINICZNE I DOŚWIADCZALNE
ISBN 978-83-61517-88-7, format A4, oprawa twarda, 496 s.,
|
![]() |
ZESPOŁY CHOROBOWE Z OBJAWAMI LARYNGOLOGICZNYMI. Kompendium
ISBN 978-83-61517-65-8, format B5, oprawa twarda, 450 s.,
|
![]() |
CHEMISTRY FOR THE FIRST YEAR STUDENTS
ISBN 978-83-61517-41-2, format B5, oprawa miękka, 88 s.,
|
![]() |
WYBRANE ZAGADNIENIA WSPÓŁCZESNEJ STOMATOLOGII
ISBN 978-83-61517-64-1, format B5, oprawa miękka, 110 s.,
|
![]() |
ZARYS STOMATOLOGII dla studentów Wydziału Lekarskiego
ISBN 978-83-61517-62-7, format B5, oprawa miękka, 134 s.,
|
![]() |
THE STORY OF THE GRADUATES OF THE POLISH SCHOOL
|
![]() |
ĆWICZENIA Z CHEMII ORGANICZNEJ dla studentów I roku Pomorskiego Uniwersytetu Medycznego
ISBN 978-83-61517-40-5, format B5, oprawa miękka, 88 s.,
|
![]() |
ENDOCRINOLOGY in clinical practice
ISBN 978-83-61517-46-7, format B5, oprawa twarda, 744 s.,
|
![]() |
REUMATOLOGIA KLINICZNA
ISBN 978-83-89318-33-7, format B5, oprawa twarda, 316 s.,
|
![]() |
FIZYKA WSPÓŁCZESNA W BADANIACH ISTOTY NATURY
ISBN 978-83-61517-30-6, format B5, oprawa miękka, 122 s.,
|
![]() |
PRAKTYCZNY PODRĘCZNIK ANATOMII CZŁOWIEKA dla studentów medycyny
ISBN 978-83-61517-20-7, format A4, oprawa miękka, 188 s.,
|
![]() |
ĆWICZENIA Z CHEMII dla studentów I roku Pomorskiej Akademii Medycznej
ISBN 978-83-61517-22-1, format B5, oprawa miękka, 106 s.,
|
![]() |
HUMAN ANATOMY FOR MEDICAL STUDENTS. Practical Textbook
ISBN 978-83-61517-10-8, format A4, oprawa miękka, 238 s.,
|
![]() |
BIOCHEMIA DLA STUDENTÓW STOMATOLOGII
ISBN 978-83-61517-17-7, format B5, oprawa miękka, 228 s.,
|
|
|
PODSTAWY CHIRURGII KLATKI PIERSIOWEJpod red. Tomasza Grodzkiego ISBN 978-83-61517-15-3, format B5, oprawa twarda, 182 s.
|
![]() |
edited by Aleksandra Kładna ISBN 978-83-89318-92-3, format B5, oprawa twarda, 195 s.
|
| ________________________ |

.jpg)
.jpg)
.jpg)
.jpg)
.jpg)
.jpg)
.jpg)

.jpg)
.jpg)
.jpg)
.png)
.jpg)
.jpg)
.jpg)
.png)
.jpg)
.jpg)
.jpg)
.jpg)
.jpg)
.jpg)
.jpg)
.jpg)
.jpg)
.jpg)
.jpg)
.jpg)
.jpg)



